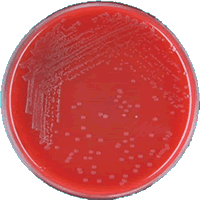

Introduction
Il s'agit du site N°1, site de 3000 truies reproductrices, avec un bon niveau de production, uniquement positif en Lawsonia intracelullaris et en PCV2. L'élevage se situe au sud de la province du Manitoba (Canada).
Tout le cheptel de renouvellement de l'élevage entrait en passant par une unité de quarantaine tout plein-tout vide partagée avec un autre élevage de 3000 truies. La durée de quarantaine de ces animaux était de 28 jours. Les mesures de biosécurité étaient bonnes, on était obligé de passer par les douches avant d'entrer dans les bâtiments. Les équipements et les fournitures étaient désinfectés préalablement avant d'entrer.

Durant l'été 2008, une sévère mortalité de truies s'est produite, environ 300 truies sont mortes sur une période de 8 semaines. L'élevage est passé d'un taux de mortalité de 1,8% à une mortalité de 6,8% le 15 juillet 2008 en plein épisode de mortalité. La mortalité sur les porcelets allaitants a été aussi élevée pendant cette période. L'élevage est parti d'une mortalité avant sevrage jusqu'au mois de juin de 11,95% atteignant des pics de 16 % en juillet pendant la crise du cas clinique.

Graphique 1 : Mortalité des truies du 1er janvier au 15 Juillet 2008

Graphique 2 : Mortalité des porcelets allaitants en juin 2008
Tableau clinique et autopsies
Tableau clinique
Le symptôme de mort subite chez les truies a été observé pour la première fois à la fin du mois de juin 2008.
Avant la mort, les truies étaient en décubitus, présentaient de la léthargie, de l'hyperesthésie et de l'anorexie.
La progression des symptômes cliniques de chaque truie était extrêmement rapide. Il était fréquent qu’elles consomment leur ration le matin puis présentent une symptomatologie clinique et meurent en fin de journée. Cette symptomatologie était différente des autres épisodes de morts soudaines que les truies ont connu précédemment pendant lesquels il n'y avait pas de symptômes cliniques préalables à la mort et que l’on avait a attribué des torsions gastro-spléniques.

Autopsies
Les autopsies ont été rapidement réalisées par le vétérinaire responsable de l'élevage, montrant des hémorragies sous-cutanées et musculaires, une péricardite fibrineuse, de la pneumonie et des reins aux multiples infarctus entourés d'un cercle hémorragique (< 1 mm). Les échantillons furent envoyés au laboratoire vétérinaire régional pour des analyses microbiologiques et histo-pathologiques.

Résultats de laboratoire
Le premier diagnostic provisoire du problème s'orientait vers une septicémie due à une souche d'Actinobacillus. Comme diagnostic différentiel, on a évoqué A. suis, Erysipelothrix rhusiopathiae, Leptospira sp, S. suis, le circovirus, la peste porcine classique et Salmonella sp.
Ensuite, au cours de la crise, des porcelets de 1 à 4 jours de vie ont été aussi envoyés au laboratoire pour un diagnostic. Ils souffraient de fièvre et d'arthrite et les autopsies ont révélé une néphrite embolique, une péritonite fibrineuse, de la périarthrite et de l’arthrite.
Ensuite, au cours de la crise, des porcelets de 1 à 4 jours de vie ont été aussi envoyés au laboratoire pour un diagnostic. Ils souffraient de fièvre et d'arthrite et les autopsies ont révélé une néphrite embolique, une péritonite fibrineuse, de la périarthrite et de l’arthrite.
Sur les truies, l'histopathologie a révélé une embolie bactérienne dans beaucoup de tissus comme les reins, la rate, les poumons et la glande surrénale.
Les cultures bactériennes ont confirmé, dans les articulations, les poumons, le foie et la rate, des niveaux élevés d'Actinobacillus equuli, une souche d'Actinobacillus typique des chevaux. La PCR a été négative en virus influenza H1N1/H3N2, en SDRP et en peste porcine classique. Les tissus pulmonaires ont été positifs en circovirus porcin par PCR mais négatifs par la méthode de l'immunohistochimie (IHC).
La bactérie isolée a été parfaitement caractérisée comme celle d'Actinobacillus equuli, sous-espèce equuli.
Mesures mises en place
À mesure que le nombre de cas augmentaient, on a mis en place un programme pour contrôler quotidiennement chaque animal dans le but d'identifier le plus tôt possible les malades. Devant le nombre élevé d'animaux qui devaient être vérifiés, on a développé un système de détection rapide. Certains salariés déterminés ont été très efficaces en repérant les symptômes précoces comme l'anorexie (baisse de la consommation d'aliment) et la léthargie (faible réponse à des stimulations tactiles). On a pris la température de ces animaux, leur localisation et on a enregistré tant les traitements administrés que la symptomatologie présentée.
Traitements antibiotiques...
Les truies ont été traitées à base d'oxytétracycline dans l'eau de boisson et d'acide acétyl-salicylique (ASA), de chlortétracycline et de tiamuline dans l'aliment. La tilmicosine a été discutée et, malgré son efficacité, on l'a rejeté à cause de son prix élevé. On a mené sur les truies une thérapie antibiotique injectable avec du ceftiofur et de la tulathromycine. Le kétoprofène a été l’anti-inflammatoire injectable de choix. Les porcelets ont été injectés à la tulathromycine ou au ceftiofur, à 7 et 14 jours d'âge.
...et autovaccin
Un isolat d'A. equuli a été envoyé au laboratoire pour la fabrication d'un autovaccin inactivé. Toutes les truies reproductrices ont été vaccinées en une seule dose 6 semaines après le début de la crise. La vaccination “booster” a été faite environ 17 jours plus tard.
Résultats
La réponse aux traitements préventifs pendant la crise a été relativement inefficace comme le montre le graphique 3. L'utilisation de l'autovaccin a été la clé dans la résolution des signes cliniques et de la mortalité des truies reproductrices.

Graphique 3 : Mortalité des truies du 1er janvier au 31 D&cembre2008
Les truies reproductrices ont eu une faible réponse aux traitements individuels. Les animaux traités individuellement ont survécu mais leur condition et leur état corporel a continué à empirer dans beaucoup de cas et ils ont été remplacés par des truies de renouvellement.
En même temps, la thérapie préventive sur les porcelets a été très efficace et la mortalité globale des porcelets en maternité a été beaucoup plus faible. L'administration d'antibiotiques longue action et à haute efficacité sur les porcelets n'avaient pas un prix aussi prohibitif que pour les truies reproductrices.

Graphique 4: Mortalité des porcelets allaitants de juin à Octobre 2008
Six mois plus tard après le cas décrit, l'élevage voisin de 3000 truies reproductrices a subi un épisode semblable dû au même pathogène.
Une leçon bien retenue !
Six mois plus tard après le cas décrit, l'élevage voisin de 3000 truies reproductrices a subi un épisode semblable dû au même pathogène.
Ces deux élevages avaient en commun les aspects suivants : le propriétaire, l'origine du cheptel de renouvellement des primipares, la quarantaine, la remorque des truies de réforme, l'origine de l'eau, la situation (uniquement séparés de 900 m) et la destination des porcelets. Les salariés n'étaient pas partagés entre les élevages mais il existait une certaine interaction entre eux pendant le transport des animaux.
Ce deuxième cas s'est solutionné rapidement puisque le vétérinaire de l'élevage et le propriétaire avaient retenu la leçon, évitant la perte d'un nombre aussi élevé de truies, car ils ont utilisé l'antibiotique de première intention, la tilmicosine, aux doses adaptées.
(NDLR : vous recevrez des précisions sur Actinobacillus equuli si vous êtes inscrit pour recevoir le commentaire par mail)
Commentaires
Il s'agit d'un site de 3000 truies reproductrices, de bonne production, uniquement positif en Lawsonia intracelullaris et en PCV2. L'élevage se situe au sud de la province de Manitoba (Canada).
Pendant l'été 2008, il s'est produit une mortalité importante des truies, environ 300 truies sur une période de 8 semaines, soit 10% du total de l'exploitation. Les truies étaient en décubitus, présentaient de la léthargie, de l'hyperesthésie et de l'anorexie. La progression des symptômes cliniques était extrêmement rapide. Elles consommaient très souvent leur ration le matin, présentaient une symptomatologie clinique et mouraient à la fin de la journée. Cette symptomatologie était différente des autres épisodes précédents de mortalité soudaine.
La cause de ces pertes a été attribuée à Actinobacillus equuli.
Les traitements dans l'aliment et dans l'eau et les traitements antibiotiques injectables ont été relativement inefficaces pour prévenir la mortalité des truies. La mortalité au pré-sevrage a augmenté de 4%, par conséquent ce fut relativement insignifiant. L'utilisation d'un autovaccin a été la clé de la réussite sur les signes cliniques et la mortalité des truies reproductrices.
Six mois plus tard après le cas décrit, un élevage voisin de 3000 truies reproductrices subit un épisode similaire dû au même pathogène. Ce cas fut rapidement résolu en utilisant l'antibiotique de premier choix, la tilmicosine, aux bonnes doses.
Actinobacillus equuli est considéré comme un pathogène commun chez les chevaux et cause parfois des septicémies fatales chez les poulains. On décrit peu de cas à Actinobacillus equuli comme pathogène opportuniste chez les porcs. Dans ces cas où on l'a isolé, on a été confronté à des avortements de la septicémie et de la polyarthrite. Alors que le contact direct porcs-chevaux a toujours été démontré lors de cas décrits dans la bibliographie, les derniers cas relatés n'ont pas ce même historique explicite. Dans le cas que l'on décrit, il n'y a pas eu de contact direct avec les chevaux.
En Amérique du Nord, l'infection des porcs par Actinobacillus equuli a été relatée très peu de fois. Il existe seulement 3 cas décrits au siècle passé.
Le cas exposé est un cas assez singulier car jamais Actinobacillus equuli n'a été la cause d'un nombre aussi élevé de pertes.
On espère que ce cas aidera les vétérinaires et les techniciens de laboratoire à connaître le risque de ces maladies considérées comme potentiellement émergentes.




